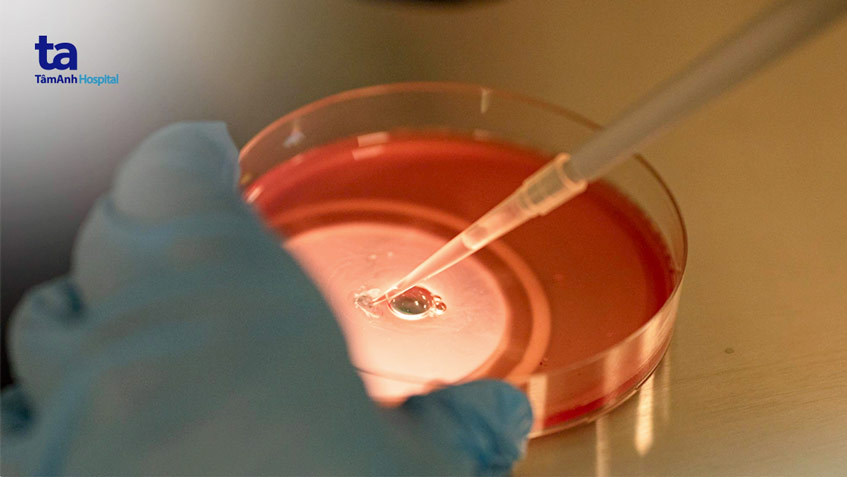

Physical Address
304 North Cardinal St.
Dorchester Center, MA 02124
Physical Address
304 North Cardinal St.
Dorchester Center, MA 02124

Việc trữ trứng (đông lạnh trứng) đang trở thành lựa chọn phổ biến cho nhiều phụ nữ hiện đại mong muốn chủ động hơn trong việc sinh sản. Tuy nhiên, “Trữ trứng bao nhiêu tiền?” hay “Chi phí trữ trứng có đắt không?” là những băn khoăn lớn của nhiều người khi tìm hiểu về phương pháp này. Bài viết dưới đây sẽ cung cấp cho bạn thông tin chi tiết về giá trữ trứng, chi phí đông lạnh trứng, bảng giá tham khảo ở Việt Nam cũng như gợi ý địa chỉ trữ trứng uy tín, giá hợp lý, giúp bạn cân nhắc lựa chọn phù hợp với nhu cầu cá nhân.
Trữ trứng ngày càng trở thành một lựa chọn phổ biến cho nhiều phụ nữ muốn bảo vệ khả năng sinh sản của mình. Chi phí cho việc trữ đông trứng tại Việt Nam dao động từ 30 triệu đến 90 triệu đồng, tùy thuộc vào từng cơ sở y tế và quy trình thực hiện. Trong số đó, Bệnh viện Từ Dũ có mức chi phí khoảng 70-80 triệu đồng cho một lần thực hiện bao gồm tất cả các bước như kích trứng và chọc hút.
Một yếu tố quan trọng khác cần lưu ý là chi phí lưu trữ hàng năm, thường dao động từ 5 đến 20 triệu đồng. Năm đầu tiên thường có giá cố định khoảng 20 triệu đồng, trong khi từ năm thứ hai trở đi, chi phí thường dao động từ 8 đến 9 triệu đồng tùy thuộc vào cơ sở y tế. Điều này có nghĩa rằng, nếu bạn quyết định trữ trứng, hãy chuẩn bị cho những khoản chi phí không nhỏ trong những năm tiếp theo.
Tuy nhiên, việc trữ trứng có thể giúp nhiều người yên tâm hơn về tương lai sinh sản của mình. Chi phí có thể là khá cao, nhưng nhiều người tin rằng đó là một khoản đầu tư xứng đáng.

Chi phí trữ đông trứng hiện nay ở Việt Nam thường dao động từ 30 đến 90 triệu đồng. Mức phí này có thể thay đổi tùy thuộc vào số lượng trứng mà bạn muốn trữ. Thực tế, tại các bệnh viện lớn như Từ Dũ, tổng chi phí cho một lần trữ trứng thường dao động từ 70 đến 80 triệu, bao gồm cả các bước kích thích và chọc hút trứng.
Ngoài khoản chi phí ban đầu, người dùng còn phải tính tới các khoản phí duy trì hàng năm. Tại Bệnh viện Từ Dũ, chi phí duy trì từ năm thứ hai trở đi là khoảng 4 triệu đồng mỗi năm, trong khi các cơ sở khác như Tâm Anh có mức phí lưu trữ từ 10 đến 17 triệu đồng.
Khi thực hiện quy trình trữ trứng, ngoài chi phí trữ, người dùng còn cần lưu ý đến các khoản chi cho thuốc kích trứng, thường dao động từ 20 đến 50 triệu đồng cho mỗi chu kỳ IVF.
Nhìn chung, các chi phí này có thể tạo áp lực tài chính không nhỏ, nhưng việc dự trữ trứng lại mang đến nhiều cơ hội cho những ai muốn thực hiện ước mơ làm mẹ trong tương lai.

Giá trữ trứng hiện nay đã trở thành một vấn đề thu hút sự quan tâm của nhiều người. Tại Việt Nam, chi phí này trung bình dao động từ 30 đến 90 triệu đồng, tùy thuộc vào số lượng trứng mà bạn muốn trữ. Vậy bạn có thể tự hỏi, chi phí này bao gồm những gì?
Một trong những chi phí đáng lưu ý là chi phí trữ đông lạnh hàng năm, thường rơi vào khoảng 5 đến 20 triệu đồng. Nếu bạn chọn Bệnh viện Từ Dũ, thì tổng chi phí trong một lần sẽ dao động từ 70 đến 80 triệu đồng, bao gồm cả tiền kích trứng và các bước tác động khác.
Đặc biệt, từ năm thứ hai, bạn sẽ phải trả thêm một khoản cố định là 4 triệu đồng mỗi năm, không phụ thuộc vào số lượng trứng hay phôi được lưu trữ. Còn tại Bệnh viện Hùng Vương, mức phí lại có phần nhẹ nhàng hơn, chỉ khoảng 45-65 triệu đồng cho việc trữ trứng, kèm theo mức phí lưu trữ hàng năm từ 8 đến 14 triệu đồng.
Khi xem xét tất cả các chi phí liên quan, rõ ràng việc trữ trứng đòi hỏi một kế hoạch tài chính hợp lý. Nhưng đây cũng chính là một bước quan trọng để bảo vệ tương lai cho chính bạn, đặc biệt là trong thời kỳ hiện đại ngày nay.

Chi phí trữ đông trứng hiện nay ở Việt Nam có nhiều biến động, thường dao động từ 30 đến 90 triệu đồng cho năm đầu tiên, tùy vào số lượng trứng và dịch vụ mà bạn chọn. Nếu bạn thực hiện trữ trứng tại Bệnh viện Từ Dũ, toàn bộ chi phí có thể lên tới 70-80 triệu đồng, bao gồm tất cả các bước như kích thích buồng trứng và chọc hút trứng.
Ngoài ra, chi phí lưu trữ hàng năm cũng là một yếu tố cần xem xét. Mỗi năm, bạn có thể phải chi từ 5 đến 20 triệu đồng cho việc lưu trữ, với khoảng 20 triệu đồng cho năm đầu tiên. Các cơ sở khác nhau cũng có mức giá khác nhau, như Mỹ Đức từ 48-70 triệu đồng cho dịch vụ trữ đông.
Tại các trung tâm hỗ trợ sinh sản, như BVĐK Tâm Anh, chi phí cho trữ phôi đông lạnh là 4,6 triệu đồng cho mỗi chu kỳ. Những yếu tố này đều ảnh hưởng đến quyết định của bạn, vì vậy hãy tham khảo kỹ trước khi đưa ra lựa chọn.

Chi phí đông lạnh trứng đang trở thành một chủ đề được nhiều phụ nữ quan tâm, đặc biệt là những ai có kế hoạch hoãn việc mang thai. Hiện tại, tại Việt Nam, chi phí này dao động từ 30 – 90 triệu đồng, tùy thuộc vào số lượng trứng muốn trữ. Nếu bạn chỉ đông một mẫu trứng, khoản chi phí khoảng 4,5 triệu đồng cho mẫu đầu tiên, và từ mẫu thứ hai trở đi là 1,2 triệu đồng/mẫu.
Ngoài ra, chi phí lưu trữ trứng đông lạnh hằng năm cũng là một điều cần lưu ý. Năm đầu tiên, bạn cần dành ra khoảng 20 triệu đồng cho việc bảo quản, nhưng từ năm thứ hai trở đi, chi phí giảm còn 8 – 9 triệu đồng mỗi năm, giúp bạn có một kế hoạch tài chính hợp lý hơn.
Nếu bạn quyết định thực hiện quy trình trữ đông trứng, tổng chi phí sẽ phụ thuộc vào nhiều yếu tố như thuốc kích thích buồng trứng và phương pháp thực hiện. Điều này có thể khiến tổng chi phí lên tới 70-80 triệu đồng. Do vậy, việc nắm rõ thông tin và chuẩn bị tài chính là rất quan trọng để thực hiện ước mơ làm mẹ trong tương lai.

Trữ đông trứng, hay còn gọi là bảo quản lạnh tế bào trứng đã trưởng thành, là một kỹ thuật hiện đại giúp phụ nữ bảo tồn khả năng sinh sản của mình. Tại Việt Nam, chi phí cho dịch vụ này thường dao động từ 30 đến 90 triệu đồng, tùy thuộc vào số lượng trứng cần được trữ.
Chi phí thực hiện ban đầu thường rơi vào khoảng 25-30 triệu đồng, bao gồm cả phí chọc hút và trữ trứng. Sau đó, giá đông lạnh cho mẫu đầu tiên là 4.5 triệu đồng, và từ mẫu thứ hai trở đi là 1.2 triệu đồng. Mỗi năm, để duy trì lưu trữ, bạn cần chi khoảng 5 đến 20 triệu đồng, tùy theo từng bệnh viện và dịch vụ hỗ trợ.
Điều này có nghĩa rằng, tổng chi phí có thể dao động từ 70 đến 80 triệu đồng cho toàn bộ quá trình, bao gồm cả thuốc và phát đồ điều trị. Trữ đông trứng không chỉ là lựa chọn cho những ai có kế hoạch sinh con muộn, mà còn giúp bảo vệ khả năng sinh sản trong tương lai.

Trữ đông trứng đang trở thành một lựa chọn ngày càng phổ biến với phụ nữ hiện đại, nhưng nhiều người vẫn băn khoăn về chi phí của quy trình này. Tại Việt Nam, chi phí cho trữ đông trứng có thể dao động từ 30 triệu đến 90 triệu đồng, tùy thuộc vào từng bệnh viện và quy trình điều trị cụ thể.
Một số cơ sở như Bệnh viện Tâm Anh, tổng chi phí lưu trữ trứng có thể lên đến 90 triệu đồng cho mỗi lần trữ. Còn với chi phí lưu trữ hàng năm, mức giá thường nằm trong khoảng 4 triệu đến 20 triệu đồng, tùy theo dịch vụ mà người bệnh chọn. Điều thú vị là chi phí lưu trữ hàng năm thường không thay đổi dù số lượng trứng hay phôi đang lưu trữ có nhiều hay ít.
Nếu bạn đang xem xét việc trữ trứng, bạn nên chuẩn bị ngân sách khoảng 50 triệu đồng cho toàn bộ quy trình ban đầu, bao gồm chi phí chọc hút và lấy trứng. Từ năm thứ hai trở đi, bạn sẽ chỉ cần lo một khoản phí lưu trữ cố định khoảng 8-9 triệu đồng mỗi năm, một mức giá khá hợp lý cho sự an tâm trong tương lai.

Trữ trứng chi phí hiện nay tại Việt Nam đang là một chủ đề được nhiều người quan tâm, đặc biệt là các chị em phụ nữ muốn bảo quản sức khỏe sinh sản. Trung bình, chi phí cho việc trữ đông trứng dao động từ 30 đến 90 triệu đồng, và có thể thay đổi tùy thuộc vào số lượng trứng mà người phụ nữ muốn bảo quản.
Để có thể thực hiện trữ trứng, trước hết, bạn sẽ cần kích thích buồng trứng và chọc hút để lấy trứng, với chi phí khoảng 60 – 70 triệu đồng cho mỗi lần thực hiện. Ngoài ra, bạn cũng phải tính đến các chi phí dịch vụ đi kèm, như phí xét nghiệm và lưu trữ, có thể lên đến 25 – 30 triệu đồng.
Một phần quan trọng nữa là chi phí trữ lạnh hàng năm, dao động từ 5 đến 20 triệu đồng, tùy thuộc vào từng bệnh viện và dịch vụ. Vì vậy, việc tính toán chi phí tổng thể là cần thiết để bạn có thể đưa ra quyết định phù hợp cho sức khỏe và tương lai của mình.

Trữ đông trứng hiện nay đã trở thành một lựa chọn phổ biến cho nhiều phụ nữ, đặc biệt là những người đang hoãn việc sinh con để tập trung vào sự nghiệp hoặc lý do cá nhân. Tuy nhiên, một câu hỏi mà nhiều người thường đặt ra là: Chi phí trữ trứng có đắt không? Trung bình, tại Việt Nam, chi phí cho việc trữ đông trứng dao động từ 30 đến 90 triệu đồng, tuỳ thuộc vào số lượng trứng muốn bảo quản.
Bên cạnh đó, chi phí hàng năm cho việc lưu trữ cũng có thể rơi vào khoảng 5 đến 20 triệu đồng. Chưa dừng lại ở đó, chi phí cho quy trình kích thích buồng trứng và chọc hút để lấy trứng thường dao động từ 60 đến 70 triệu đồng cho mỗi lần thực hiện. Nếu may mắn, một lần chọc hút có thể thu được khoảng 15 trứng, nhưng đến cuối cùng, người phụ nữ vẫn phải chi thêm từ 10 đến 15 triệu đồng cho số trứng này.
Tóm lại, mặc dù chi phí trữ trứng có thể khá cao và phụ thuộc vào nhiều yếu tố khác nhau, nhưng nhiều phụ nữ vẫn sẵn lòng đầu tư cho tương lai của mình. Trữ đông trứng không chỉ là một lựa chọn mà còn là một cách bảo vệ cơ hội sinh con cho những năm tháng sau này.

Trữ trứng hiện đang trở thành lựa chọn phổ biến cho nhiều chị em phụ nữ muốn bảo vệ khả năng sinh sản của mình. Chi phí cho dịch vụ này ở Việt Nam dao động từ 30 đến 90 triệu đồng. Thực tế, chi phí trữ trứng lần đầu thường nằm trong khoảng 40-50 triệu đồng, bao gồm cả quá trình kích thích buồng trứng và chọc hút trứng.
Sau khi thực hiện, bạn sẽ cần chi một khoản phí hàng năm để bảo quản trứng, thường từ 5 đến 20 triệu đồng mỗi năm. Nếu lựa chọn các cơ sở y tế uy tín như Bệnh viện Từ Dũ hoặc Vinmec, chi phí có thể cao hơn, dao động từ 60-80 triệu đồng cho mỗi lần thực hiện. Đây là một khoản đầu tư cho tương lai mà nhiều chị em cảm thấy xứng đáng.
Mặc dù chi phí có thể cao, nhưng dịch vụ này đảm bảo sẽ được thông báo rõ ràng và minh bạch ngay từ đầu, giúp người sử dụng không lo lắng về những chi phí bất ngờ. Tóm lại, việc trữ trứng là một lựa chọn cần thiết và đáng cân nhắc, nhất là trong bối cảnh cuộc sống hiện đại ngày nay.
Kết thúc bài viết, chúng ta có thể thấy rằng việc trữ trứng là một quyết định quan trọng đối với nhiều phụ nữ trong việc bảo vệ quyền tự quyết về sinh sản của mình. Giá thành cho một lần trữ trứng không hề nhỏ, thường dao động từ vài triệu đến hàng chục triệu đồng, tùy thuộc vào nơi thực hiện và phương pháp áp dụng. Tuy nhiên, đây là một khoản đầu tư xứng đáng cho tương lai, đảm bảo cho cơ hội mang thai sau này. Hãy cân nhắc kỹ lưỡng và tìm hiểu kỹ càng trước khi quyết định để đảm bảo cho sự an toàn và hiệu quả.